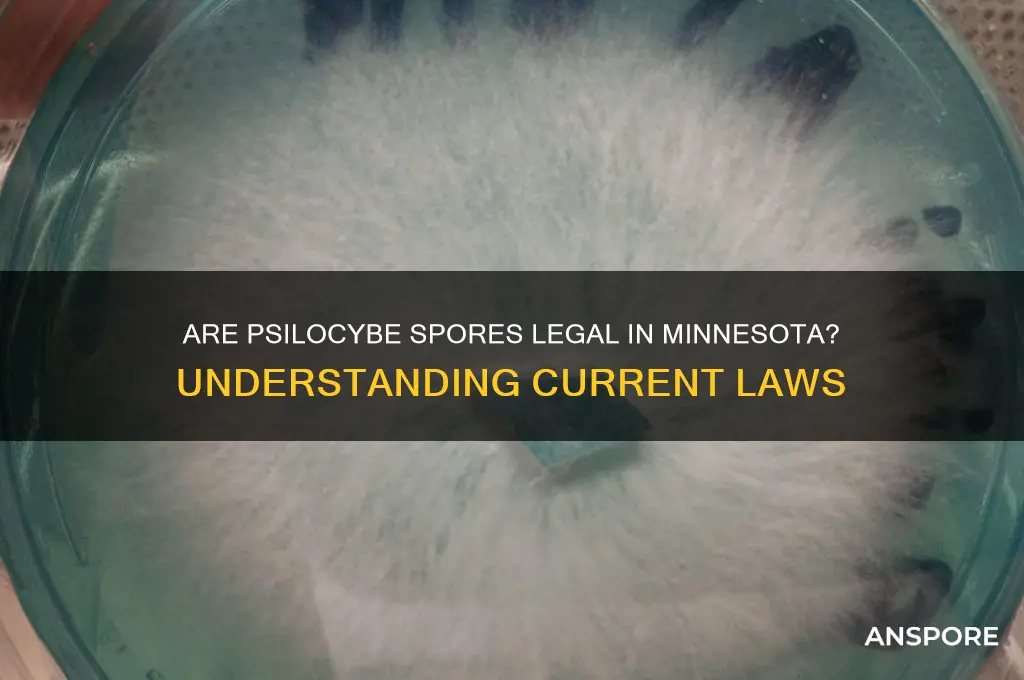
are psilocybe spores legal in minnesota

In Minnesota, the legal status of psilocybe spores is a nuanced and often misunderstood topic. Psilocybe spores themselves are not explicitly classified as a controlled substance under state law, primarily because they do not contain psilocybin or psilocin, the psychoactive compounds found in mature mushrooms. However, cultivating these spores into mushrooms that produce these substances is illegal, as psilocybin mushrooms are classified as Schedule I controlled substances in both Minnesota and under federal law. As a result, while possessing psilocybe spores for microscopy or educational purposes may be permissible, using them to grow mushrooms for consumption or distribution is strictly prohibited and can lead to severe legal consequences. This distinction highlights the importance of understanding the specific intent and use of the spores when navigating their legality in Minnesota.
| Characteristics | Values |
|---|---|
| Legal Status of Psilocybe Spores | Legal for microscopy, illegal for cultivation or consumption |
| State | Minnesota |
| Federal Law | Psilocybin (active compound) is Schedule I controlled substance; spores themselves not explicitly illegal under federal law |
| Minnesota State Law | No specific law addressing psilocybe spores; cultivation or possession of psilocybin mushrooms is illegal |
| Intent | Spores legal if intended for microscopy or research; illegal if intended for cultivation or consumption |
| Penalties for Cultivation/Possession | Felony charges, fines, and imprisonment (varies based on quantity and intent) |
| Decriminalization Efforts | No active decriminalization efforts in Minnesota as of latest data |
| Medical Use | Not approved for medical use in Minnesota; psilocybin therapy not legalized |
| Local Ordinances | Some cities/counties may have additional regulations; check local laws |
| Online Purchase | Legal to purchase spores online for microscopy; vendors often include disclaimers about intent |
| Enforcement | Low priority for law enforcement; focus typically on cultivated mushrooms or psilocybin |
Explore related products
What You'll Learn

Current Minnesota Psilocybe Spores Laws
In Minnesota, the legal status of psilocybe spores hinges on their intended use. While psilocybin, the psychoactive compound found in certain mushrooms, is classified as a Schedule I controlled substance under both federal and state law, the spores themselves occupy a gray area. Psilocybe spores do not contain psilocybin and are technically legal to possess and sell in Minnesota for non-cultivation purposes, such as microscopy or collection. However, the moment these spores are used to cultivate mushrooms containing psilocybin, the act becomes illegal, carrying significant penalties.
This distinction creates a nuanced legal landscape. Vendors in Minnesota often sell psilocybe spores with disclaimers emphasizing their legality for research or educational purposes only. For instance, a popular spore vendor might label their products as "for microscopy use only" to avoid liability. Despite this, law enforcement and prosecutors may still scrutinize possession of spores, particularly if there is evidence of intent to cultivate. This could include the presence of growing equipment, such as grow kits or mycology guides, which could be used to build a case for illegal activity.
For individuals considering purchasing psilocybe spores in Minnesota, caution is paramount. While possession of spores alone may not result in charges, the risk increases dramatically if cultivation is suspected. Penalties for cultivating psilocybin mushrooms can include fines, imprisonment, and a criminal record. For example, under Minnesota Statutes § 152.021, manufacturing a controlled substance like psilocybin can result in up to 30 years in prison and a $1 million fine, depending on the quantity produced. Even small-scale cultivation for personal use carries severe consequences, with potential sentences of up to 5 years and $10,000 in fines.
Comparatively, other states have begun to decriminalize or legalize psilocybin for medical or therapeutic use, such as Oregon and Colorado. Minnesota, however, remains firmly within the traditional legal framework, treating psilocybin as a dangerous drug. This contrasts sharply with the growing body of research supporting psilocybin’s therapeutic potential for conditions like depression, PTSD, and anxiety. Advocates in Minnesota are pushing for reform, but until legislation changes, the current laws remain strict and unforgiving.
In practical terms, individuals interested in psilocybe spores should focus on legal, non-cultivation uses, such as studying spore structures under a microscope. Investing in a quality microscope (e.g., a 40X-1000X model) and proper slide preparation tools can enhance the educational experience. Additionally, joining mycology clubs or online forums can provide a community for legal exploration of fungi without crossing legal boundaries. While the allure of cultivation may be strong, the legal risks in Minnesota far outweigh the benefits, making compliance with current laws the safest course of action.
Are Mould Spores Dangerous? Understanding Health Risks and Prevention
You may want to see also

Federal vs. State Regulations on Spores
The legality of psilocybe spores in Minnesota hinges on a critical distinction: federal versus state regulations. Federally, psilocybin, the psychoactive compound found in magic mushrooms, is classified as a Schedule I controlled substance under the Controlled Substances Act. However, psilocybe spores themselves, which do not contain psilocybin, occupy a legal gray area. The DEA has not explicitly outlawed spores because they are not a psychoactive material, but their cultivation into mushrooms is illegal. This federal loophole allows spores to be sold and possessed for "educational" or "research" purposes, though intent matters significantly.
Minnesota’s state laws mirror federal regulations in criminalizing psilocybin and psilocin, the active compounds in magic mushrooms. However, like federal law, Minnesota does not explicitly address psilocybe spores. This omission creates ambiguity, as spores are often marketed as "novelty items" or for microscopy purposes. Practically, this means possession of spores in Minnesota is not explicitly illegal, but cultivating them into mushrooms is a felony. Law enforcement and prosecutors focus on the end product (mushrooms) rather than the spores themselves, but intent can still be scrutinized.
For those navigating this legal landscape, the key is understanding the distinction between spores and mushrooms. Spores are legal to possess in Minnesota, but their cultivation is not. If you’re purchasing spores, ensure the vendor clearly labels them for microscopy or educational use. Avoid any language suggesting cultivation, as this could attract legal attention. Additionally, keep documentation of your purchase and intended use to demonstrate compliance with the law. While the federal and state frameworks leave room for spore possession, the line is thin, and crossing it can lead to severe penalties.
A comparative analysis reveals how federal and state laws interact in this context. Federally, the focus is on the psychoactive compounds, leaving spores unregulated due to their inert nature. Minnesota’s laws align with this approach but lack specificity, creating a de facto tolerance for spore possession. This contrasts with states like California or Idaho, where spores are explicitly banned. The takeaway is that while spores are technically legal in Minnesota, their possession is not risk-free. Intent and context matter, and staying within the bounds of "educational" use is crucial to avoiding legal repercussions.
Instructively, if you’re considering purchasing psilocybe spores in Minnesota, follow these steps: first, research reputable vendors who clearly state their products are for microscopy or educational purposes. Second, avoid any actions that could imply cultivation, such as purchasing grow kits or discussing cultivation methods. Third, store spores in a secure, private location to avoid misinterpretation. Finally, stay informed about legislative changes, as both federal and state laws could evolve. While the current legal framework allows spore possession, it’s a delicate balance that requires caution and awareness.
Bacterial Spores: Their Role in Reproduction and Survival Explained
You may want to see also

Legal Penalties for Possession in MN
In Minnesota, possession of psilocybe spores—the precursor to psychedelic mushrooms—exists in a legal gray area. While spores themselves are not explicitly outlawed due to their lack of psychoactive compounds, cultivating them into mushrooms is illegal under state law. This distinction creates confusion, but the penalties for possession of cultivated mushrooms are clear and severe.
Minnesota classifies psilocybin mushrooms as a Schedule I controlled substance, placing them alongside heroin and LSD. Possession of any amount can result in felony charges, with penalties escalating based on quantity. For small amounts (under 1.5 grams), individuals face up to 5 years in prison and a $10,000 fine. Possession of 1.5 to 5 grams increases the penalty to up to 10 years and a $20,000 fine. Larger quantities (over 5 grams) can lead to up to 30 years in prison and a $1 million fine, as the law assumes intent to distribute.
First-time offenders may be eligible for diversion programs, which offer treatment instead of incarceration. However, these programs are not guaranteed and depend on judicial discretion. Repeat offenders face harsher consequences, including mandatory minimum sentences and a permanent criminal record that can impact employment, housing, and educational opportunities.
Practical tip: If you’re caught with psilocybin mushrooms, remain silent and request an attorney immediately. Minnesota’s laws prioritize prosecution, and even small mistakes in handling the situation can worsen outcomes. Additionally, avoid discussing cultivation or intent, as this can strengthen the case against you.
In summary, while psilocybe spores may skirt legality, the mushrooms they produce carry significant risks. Understanding Minnesota’s penalties underscores the importance of awareness and caution in navigating this legal landscape.
Are All Spores Diploid? Unraveling the Genetic Makeup of Spores
You may want to see also
Explore related products

Loopholes in Minnesota's Psilocybin Laws
In Minnesota, psilocybin mushrooms are classified as a Schedule I controlled substance, making their possession, cultivation, and distribution illegal. However, the law does not explicitly address psilocybe spores, which are the starting point for growing these mushrooms. This omission creates a legal gray area that some individuals and businesses exploit. Psilocybe spores themselves do not contain psilocybin, the psychoactive compound, and are often sold for "research" or "educational" purposes. This loophole allows vendors to legally sell spores in Minnesota, though germinating them into mushrooms remains illegal.
One practical example of this loophole is the widespread availability of spore syringes and spore prints online and in some local shops. These products are marketed as tools for microscopy or taxonomic study, with disclaimers warning against cultivation. However, the ease of access and the lack of enforcement create an environment where individuals can acquire spores with minimal risk of legal repercussions. For instance, a hobbyist could purchase a spore syringe for $20–$30, containing millions of spores, and theoretically begin the cultivation process without violating the letter of the law—until the spores develop into mycelium or mushrooms.
Another loophole lies in the ambiguity surrounding "intent." Minnesota law penalizes the possession of psilocybin mushrooms but does not clearly define the legality of possessing spores with the intent to cultivate. This ambiguity allows individuals to argue that their spores are for legal purposes, such as microscopy, even if their true intent is cultivation. Courts have yet to establish a consistent precedent for prosecuting spore possession based on intent, leaving this area largely untested. For those navigating this gray area, it’s crucial to document any legitimate research or educational activities to support a legal defense if questioned.
A third loophole involves the growing trend of "psilocybin decriminalization" movements in other states, which may influence Minnesota’s future policies. While Minnesota has not decriminalized psilocybin, the success of such initiatives elsewhere could embolden local advocates to push for similar reforms. In the meantime, some individuals exploit the current legal ambiguity by cultivating small amounts of mushrooms for personal use, betting on lenient enforcement or the possibility of future decriminalization. However, this approach carries significant risks, including potential felony charges if caught.
To navigate these loopholes safely, individuals should focus on legal alternatives like participating in clinical trials or advocating for policy changes. For example, the FDA has designated psilocybin as a "breakthrough therapy" for treatment-resistant depression, opening doors for regulated research. Minnesota residents can join ongoing studies or petition lawmakers to expand access to psilocybin-assisted therapy. While the loopholes in Minnesota’s psilocybin laws offer temporary opportunities, they are no substitute for systemic reform that prioritizes public health and scientific progress.
Effective Methods to Eliminate Fungal Spores and Prevent Growth
You may want to see also

Recent Legal Changes in MN (2023)
In 2023, Minnesota took a significant step in the evolving landscape of psychedelic legality by introducing legislation that directly impacts the status of psilocybe spores. The state’s lawmakers proposed a bill to decriminalize the possession and cultivation of psilocybe spores for personal use, marking a departure from previous restrictions. This move aligns with growing national interest in the therapeutic potential of psychedelics, particularly psilocybin, the active compound found in these mushrooms. While the bill does not legalize the consumption of psilocybin itself, it creates a legal gray area for those interested in studying or cultivating the spores for research or personal growth.
The proposed legislation specifies that individuals over the age of 21 can possess up to 2 ounces of psilocybe spores without facing criminal penalties. This change reflects a shift toward harm reduction and acknowledges the distinction between spores, which are inert and do not contain psilocybin, and the mature mushrooms, which do. However, it’s crucial to note that cultivating the spores into fruiting mushrooms remains illegal under state law, as the resulting fungi contain psilocybin, a Schedule I controlled substance. This nuanced approach allows for exploration of the spores’ potential while maintaining boundaries around psychoactive use.
One practical takeaway for Minnesotans is the importance of understanding the legal distinctions between spores and mushrooms. For those interested in mycology or research, purchasing spores from reputable vendors for microscopy or educational purposes is now a lower-risk endeavor. However, any attempt to cultivate the spores into mushrooms could result in severe legal consequences, including fines or imprisonment. Additionally, the bill encourages individuals to stay informed about local ordinances, as some municipalities may impose stricter regulations despite the state’s more lenient stance.
Comparatively, Minnesota’s approach mirrors trends in states like California and Oregon, where psilocybe spores are legal to possess but not to cultivate for psychoactive purposes. This middle-ground strategy aims to balance public safety with the growing demand for psychedelic research and personal exploration. Advocates argue that such measures pave the way for future legalization of psilocybin therapy, which has shown promise in treating conditions like depression, PTSD, and anxiety. Critics, however, caution against premature deregulation, emphasizing the need for rigorous oversight to prevent misuse.
In conclusion, Minnesota’s 2023 legal changes represent a cautious yet progressive step in the psychedelic landscape. By decriminalizing psilocybe spores, the state opens doors for research and personal study while maintaining strict controls on psychoactive use. For residents, this shift offers new opportunities but also requires careful navigation of the legal framework. As the conversation around psychedelics continues to evolve, Minnesota’s approach serves as a noteworthy example of how states can adapt to emerging scientific and cultural trends.
Plant Cuticles vs. Spores: Understanding Their Unique Roles and Differences
You may want to see also
Frequently asked questions
Psilocybe spores themselves are legal to possess in Minnesota, as they do not contain psilocybin, the controlled substance. However, cultivating them into mushrooms is illegal under state law.
Yes, psilocybe spores can be legally purchased in Minnesota for research, educational, or taxonomic purposes, as long as there is no intent to cultivate them into mushrooms containing psilocybin.
No, growing psilocybe mushrooms from spores is illegal in Minnesota, as the resulting mushrooms contain psilocybin, a Schedule I controlled substance under state and federal law.
There are no exceptions for personal cultivation of psilocybe mushrooms in Minnesota. However, spores remain legal for non-cultivation purposes, such as microscopy or research, as long as they are not used to produce psilocybin.

























